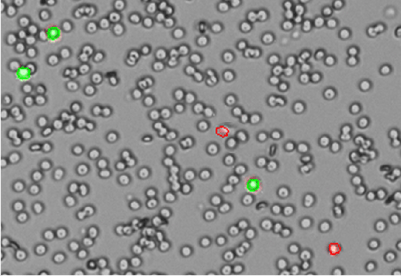
Whole Blood 400 x 275

Which Cell Counter Works Best for Clumpy / Primary Cells?
The DeNovix CellDrop™ Automated Cell Counter is an excellent choice for reliably counting primary cells, especially those with clumps. CellDrop’s software algorithms identify individual cells within clumps and report reliable cell counts and viability. With fluorescence assays like AO/PI, even primary cell samples with large amounts of debris can be quickly and accurately quantified.
Introduction
Accurately quantifying primary cells, especially when they form clumps or contain cellular debris, is a common challenge in life science research. Manual cell counting methods using Trypan Blue and hemocytometers often produce inconsistent results, particularly with heterogeneous samples like PBMCs or stem cells.
The CellDrop Automated Cell Counter simplifies the process of counting clumped primary cells with advanced imaging algorithms and fluorescence assays, enabling precise cell counts and viability analysis even in highly aggregated primary cell suspensions.
Why Are Primary Cells Important in Life Science Research?
In contrast to continuous cell lines, which can adapt to lab conditions over time, primary cells offer a better reflection of how a cell might behave in its natural environment. This is because primary cells are isolated from live tissues and are therefore considered more physiologically relevant. Primary cell lines are especially important for research areas such as drug discovery and toxicology, cancer research, regenerative medicine, and more.1
The Challenge of Counting Primary Cells
In order to ensure sample integrity for downstream workflows, it’s important to perform quality control checks of primary cell samples to enumerate the number of cells of interest and their viability. However, primary cells offer some challenges in getting accurate cell counts.
As a result of digestion, primary cell suspensions often contain a heterogeneous collection of cell types and cellular debris. They are also known to aggregate (clump) together in groups that make it difficult to distinguish individual cells.
When counting with traditional methods like a hemocytometer and Trypan Blue, it can be challenging to differentiate between primary cells, cells of non-interest, and debris. Combined with user-to-user variability, cell concentration counts are likely to have a lack of consistency between them.
How the CellDrop Provides Accurate Counts for Clumpy / Primary Cells
The DeNovix CellDrop Automated Cell Counter is a revolutionary device that allows users to count cells without slides. But its plastic and cost-saving benefits aren’t the only thing scientists love about it—it also does an exceptional job at quantifying clumpy, debris-laden samples like primary cells.
During measurement, the CellDrop software uses advanced algorithms to detect and correctly identify cells that are in clumps. Because of this, users can have confidence that their samples are being counted correctly, even for highly aggregated and complex primary cell samples.
Another reason why the CellDrop works so well for primary cell samples is the use of fluorescent dyes. As mentioned, traditional methods using colorimetric dyes like Trypan Blue present challenges for counting primary cells. In addition to debris that might mistakenly be counted as a cell, primary cells such as PBMCs are also difficult to distinguish from other cells of non-interest, like red blood cells.
Acridine Orange and Propidium Iodide (AO/PI) is a combination fluorescent dye that binds only to nucleated cells (such as primary cells). Live cells fluoresce green, and dead cells fluoresce red. Non-nucleated cells and cellular debris are not stained, and therefore, they do not interfere with counts. That means that AO/PI enables the specific identification of live / dead cells—even in the presence of large numbers of non-nucleated cells and cellular debris.
Click here for an application note about using CellDrop for accurate counts of PBMCs.
Primary Cell Types that can be Counted on the CellDrop Automated Cell Counter
The CellDrop Automated Cell Counter has been used to reliably count a variety of primary cell types. Some common primary cell types that CellDrop works well for include:
- Mouse and Human PBMCs
- PBMCs in Whole Blood
- T-Cells
- Lymphocytes
- Fibroblasts
- Stem Cells
- Neurons
- Hepatocytes
- And Many More!
Don’t see your cell type on this list? Don’t worry! The CellDrop software can be customized to accommodate a wide range of cell types. Get in touch with our Application Scientists team to ask about the cells you work with.
Try the CellDrop with Your Primary Cells
The CellDrop Automated Cell Counter is a reliable method for achieving accurate counts of clumpy primary cells. Want to try CellDrop with your samples? Click here to learn more about our 7-Day Free Trial program.
References
- An Introduction to Primary Cell Culture Systems. Cell Culture Collective. (2024, November 3). https://cellculturecollective.com/blog/an-introduction-to-primary-cell-culture-systems/?srsltid=AfmBOorHGIJ8eJbcDXQls-xAxVgsTxIXcCapKpsu_SN0Xbn5w9bFTYxA